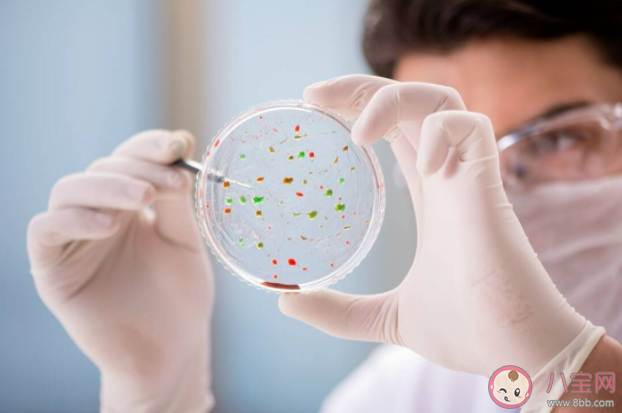
水痘和带状疱疹有什么区别 没得过水痘会得带状疱疹吗 水痘和带状疱疹有什么区别 没得过水痘会得带状疱疹吗

得过水痘的人,得带状疱疹的几率会比较大,但这不意味着没得过水痘就不会得带状疱疹,那么,水痘和带状疱疹有什么区别?下面八宝网小编就带来介绍。
水痘和带状疱疹有什么区别
带状疱疹和水痘都是由潜伏在体内的「水痘-带状疱疹病毒」引起的感染性疾病。
初次感染表现为水痘,治愈后,病毒会继续潜伏在体内,随着年龄增长,身体免疫机能退化时(尤其50岁以上),病毒就会再次被激活,引发带状疱疹。
水痘和带状疱疹,两者是同一病原体,但是也有一定的区别:
1、发病时间不同:水痘是初次感染后发生,带状疱疹是水痘感染后潜伏于人体中再发病。所以水痘青少年患病较多,而带状疱疹患者年纪比较大,成人或者老年人发病率比较高;
2、表现形式不同:水痘主要表现为全身分布,以躯干为主的红斑、水疱,可以有糜烂,有很强的传染性。带状疱疹主要局限于身体的某部位,通常呈单侧、单部位发作。如果免疫力比较低,也可能泛发,但比较少;
3、传染性不同:水痘传染性较强,青少年中经常因水痘导致学校全部停课或者隔离。而带状疱疹传染性比较低,如有发作不需要大面积隔离或者停工、停课。

没得过水痘会得带状疱疹吗
没得过水痘,并不能作为判断体内有无这种病毒的标准。因为在带状疱疹患者中,大约有30%的患者感染过病毒,却未发过水痘,即为「隐性感染」。可见该病毒之狡猾,防不胜防。
带状疱疹最让人恐惧的地方,在于会引发令人难以忍受的神经痛,对患者造成极大折磨。等到病发时再治疗,虽能治好,但也可能落下后遗症,而且期间的剧烈病痛真不是一般人能承受的,白白受罪。
对于带状疱疹,我们是完全有机会将它扼杀在摇篮中,就是及时接种带状疱疹疫苗。然而遗憾的是,带状疱疹疫苗在我国老年人群中接种率并不高。
目前带状疱疹疫苗已经相当成熟,能从根源降低发病风险。带状疱疹有复发的风险,不管有没有得过,我们都建议带家中≥50岁的长辈接种疫苗。

以上就是有关全部内容介绍,想了解更多信息请继续关注。